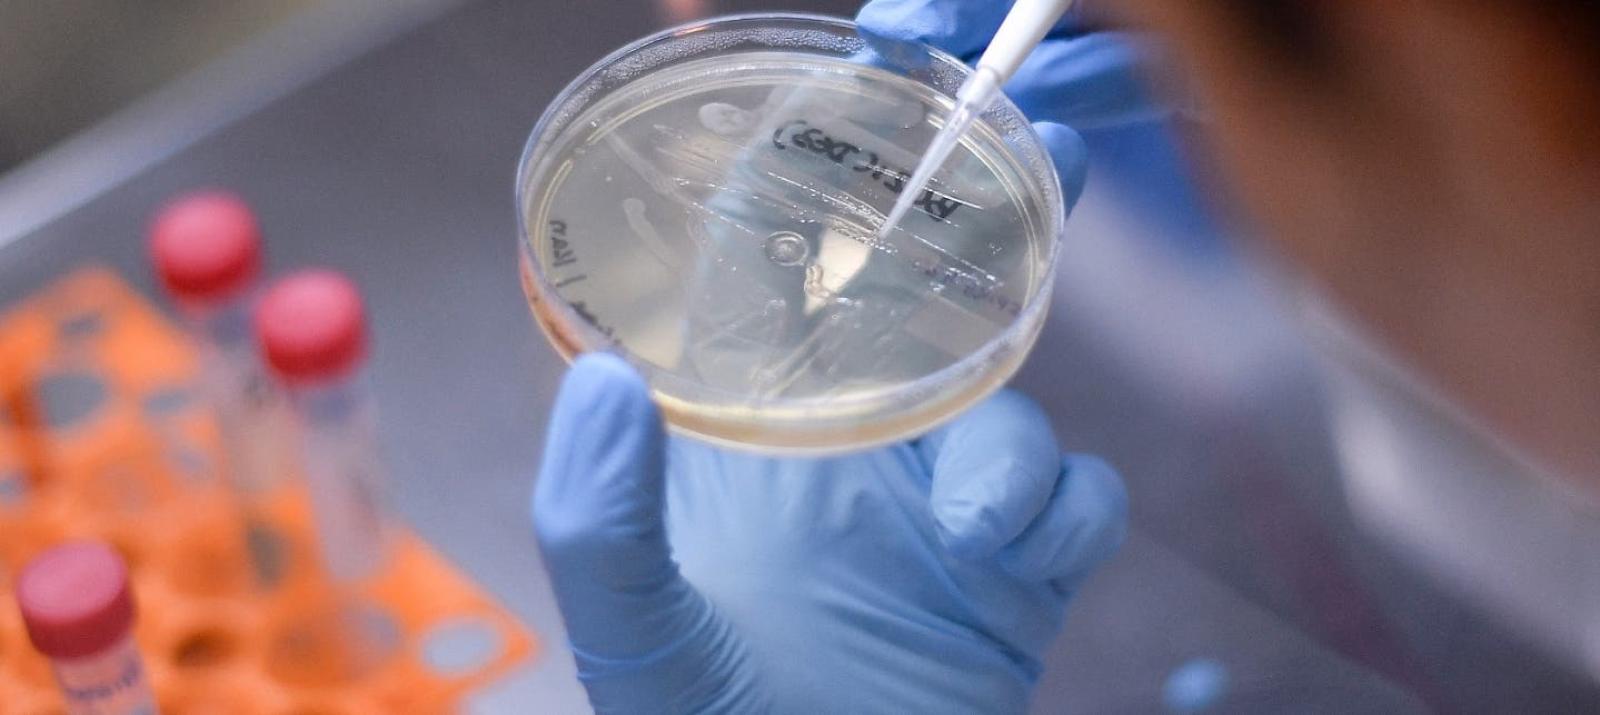

Científicos de EEUU prueban con éxito una posible vacuna contra coronavirus en ratones
Científicos de EEUU prueban con éxito una posible vacuna contra coronavirus en ratones
Científicos de EEUU prueban con éxito una posible vacuna contra coronavirus en ratones
T13 En Vivo
Científicos de la Facultad de Medicina de la Universidad de Pittsburgh, en Pensilvania, Estados Unidos, aseguran tener en desarrollo una posible vacuna contra el nuevo coronavirus, causante de la pandemia del Covid-19 que afecta al mundo entero.
Probada en ratones, la vacuna se administra a través de un parche del tamaño de la punta de un dedo y produce anticuerpos específicos para el virus, en cantidades que se consideran suficientes para neutralizarlo.
Los detalles aparecen en un artículo en EBioMedicine, publicado por The Lancet, y según describen, los investigadores lograron avanzar porque ya tenían conocimiento sobre las primeras epidemias de coronavirus.
“Teníamos experiencia previa en SARS-CoV en 2003 y MERS-CoV en 2014. Estos dos virus, que están estrechamente relacionados con el SARS-CoV-2 (el nuevo coronavirus), nos enseñan que una proteína en particular es importante para inducir inmunidad contra el virus. Sabíamos exactamente dónde combatir este nuevo virus”, expresó Andrea Gambotto, coautor del estudio y profesor en la Facultad de Medicina de la universidad.
“Por eso es importante financiar la investigación de vacunas. Nunca se sabe de dónde vendrá la próxima pandemia”, añadió.
Por su parte, el coautor Louis Falo, profesor y presidente de Dermatología en la Facultad de Medicina, destacó que “nuestra capacidad para desarrollar rápidamente esta vacuna fue el resultado de científicos con experiencia en diversas áreas de investigación que trabajan juntos con un objetivo común”.
En relación a otras posibles curas que se han intentado desarrollar, esta vacuna que describe el documento tiene un enfoque más establecido, utilizando elementos para desarrollar inmunidad. La misma forma en que actúan las vacunas contra las actuales gripes.
De acuerdo a la publicación, la administración es a través de un novedoso parche del tamaño de la punta de los dedos, el cual adherido a la piel simplemente se disuelve.
Al ser probada en los ratones, la vacuna generó anticuerpos contra el SARS-CoV-2 dentro de las dos semanas posteriores. Sin embargo, los animales no han sido rastreados a largo plazo, aunque los investigadores sostienen que la cantidad de anticuerpos producida es suficiente para neutralizar el virus por al menos un año.
Los autores del estudio ahora están en el proceso de solicitar a la Administración de Alimentos y Medicamentos de Estados Unidos (FDA por su sigla en inglés) la aprobación de un nuevo medicamento, antes de poder comenzar con la fase I de los ensayos clínicos en humanos durante los próximos meses.











